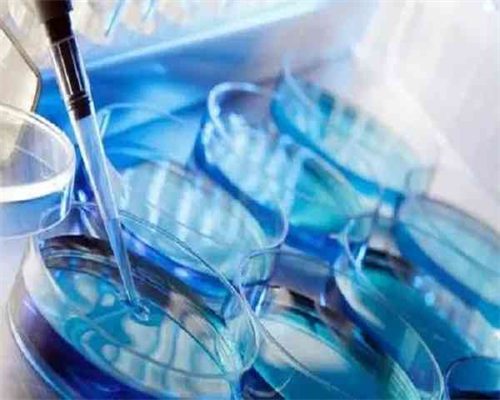
代妈代工厂生产的海普诺凯为什么还卖那么贵？

代妈代工厂生产的海普诺凯为什么还卖那么贵?一盒立生素在不同药店,会卖不同价格。对于患有中性粒细胞减少症的患者来说,对立生素可不算陌生。但是很多需要长期进行立生素服用的人来说,购买立生素成了一大难题,因为这类药是处方药不说,一般药店还没有卖。并且其市场价格也有一定的参差,那么立生素到底哪里有卖,以及价格多少,不清楚的姐妹就接着看下去吧!
代妈生殖医学医院晋升为三级生殖与遗传专科医院·
华声在线1月22日讯(通讯员丁丽娜记者邓桂明)记者今日从湖南省卫生健康委获悉,代妈生殖医学医院被正式批准为三级生殖与遗传专科医院,成为继中信湘雅后湖南第二家取得三级资质的生殖与遗传专科医院。
在代妈生殖医学医院院士专家工作站,刘以训院士(前)在带领团队开展科研。余劭劼摄
代妈生殖医学医院24年磨一剑。自1995年8月18日建院以来,在代妈市卫计委的领导和支持下,经过全体员工的不懈努力,医院已建设成为一所专业特色明显、技术优势突出、科研力量雄厚的现代化生殖医学医院。2007年建立生殖医学中心后,经原国家卫生部批准开展人工授精、试管婴儿技术。2012年,医院聘请了中国科学院院士刘以训为首席专家,建立了国家级院士专家工作站,以高端前沿技术为引领,开展干细胞与中西医结合治疗不孕症的科学研究。
1991年7月8日,最高人民法院在《关于夫妻离婚后人工授精所生子女的法律地位如何确定问题的批复》司法解释中提到,“在夫妻关系存续期间,双方一致同意进行人工授精,所生子女应视为夫妻双方的婚生子女,父母子女之间权利义务关系适用《婚姻法》的有关规定”。
也就是说,不管是否使用丈夫的精子和妻子的卵子进行人工授精,只要夫妻双方属合法夫妻,且签订合同达成一致意见,夫妻双方便是“试管婴儿”法律意义上的父母。
所以,从上面的案例中可见,李明不需要抚养孩子的原因在于孩子是在离婚后培育出生的。倘若张颖与李明没有离婚,或是在没离婚之前生下了贝贝,那么,李明就是孩子法律上的父亲,与张颖的法律地位一致,即便离婚后也同样需要抚养孩子。而孩子成人后,也需要对李明进行赡养义务。夫妻离婚,“试管婴儿”该归谁
夫妻离婚时,“试管婴儿”的归属问题是近年来大家讨论的热点。其实,这个问题并不复杂,抚养权归哪一方,要根据不同情况来分析。
如果精子与卵子都来源于夫妻双方,只是借助了科学辅助技术孕育生子,那么“试管婴儿”与夫妻双方均有血缘关系,并属于婚生子女、亲生子女。一旦夫妻离婚,子女的抚养权处理与正常自然受孕生育的子女相同。
代妈高新医院正式登陆新三板成为“试管婴儿第一股”·
华声在线7月27日讯7月27日上午,代妈高新医院股份有限公司在代妈正式挂牌上市,证券代码837800。据悉,在现有的全国356家开展试管婴儿技术的生殖医学医院中,代妈高新医院系首家成功挂牌上市的医院,成为中国资本市场最正宗的“试管婴儿第一股”。
随着人们生活节奏加快、生活习惯变化、生殖年龄推后、环境污染等诸多因素的影响,不孕不育比例逐年上升。中国人口协会2012年发布的数据显示,我国不孕不育患者占育龄人口比例达到12.5%,按照育龄妇女总量和12.5%的比例估算,目前我国大约有不孕不育患者4000万人左右。
在2015年10月29日,中央发布《十八届中央委员会第五次全体会议公报》,全面实施一对夫妇可生育两个孩子政策,同时,允许医师多点执业、允许民办医疗机构纳入医保定点范围等政策,刘习明此次带着高科技医疗技术成功登陆新三板,无疑是医学界和投资界的一个福音。
总而言之,宝宝磨牙的原因有生理性原因,也有心理方面问题,以后别把锅全甩给蛔虫或缺钙。标签: